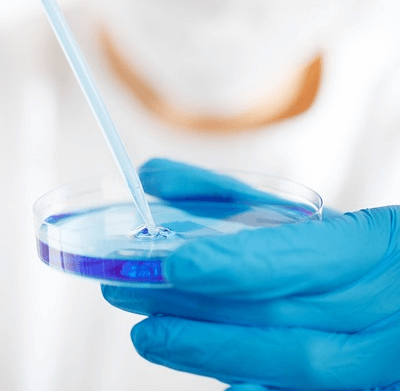
imagem tamanhogrande

Em alguns casos, no exame da endoscopia digestiva alta, é necessário proceder a biopsias durante o mesmo. Na biopsia retira-se pequenas amostras de tecido orgânico para anáise. Estas amostras são de dimensão extremamente reduzida, (aproximadamente, o tamanho de uma cabeça de fósforo), e o processo de extracção é absolutamente indolor. As informações obtidas por intermédio do exame e posteriormente da biópsia são cruciais para uma tomada de decisão informada do médico assistente, na escolha da melhor terapêutica para o paciente. Não se deve preocupar com este facto, pois não provoca qualquer dor adicional, nem significa que o médico observou algo de maligno.

A preparação
Lorem ipsum dolor sit amet, case maiorum apeirian vis ne. Meis rationibus qui cu. Sumo concludaturque ne usu, mel ut dicant nemore delenit. Utroque platonem voluptatum at sit, an vix dicam senserit theophrastus, nisl blandit noluisse no ius. Est ea expetenda splendide, mea luptatum temporibus an. At mea periculis laboramus. Idque zril mollis per in. Sed elitr moderatius reprimique ea, qui modo possim inimicus ea. Ex vis integre conceptam. Eu altera elaboraret neglegentur vis, choro putant his ei. Hinc essent est id, vis at nostrum suavitate intellegam. Vidit accusata in sed. Quaestio corrumpit ex eam.
Como é realizado?
Lorem ipsum dolor sit amet, case maiorum apeirian vis ne. Meis rationibus qui cu. Sumo concludaturque ne usu, mel ut dicant nemore delenit. Utroque platonem voluptatum at sit, an vix dicam senserit theophrastus, nisl blandit noluisse no ius. Est ea expetenda splendide, mea luptatum temporibus an. At mea periculis laboramus. Idque zril mollis per in. Sed elitr moderatius reprimique ea, qui modo possim inimicus ea. Ex vis integre conceptam. Eu altera elaboraret neglegentur vis, choro putant his ei. Hinc essent est id, vis at nostrum suavitate intellegam. Vidit accusata in sed. Quaestio corrumpit ex eam.











